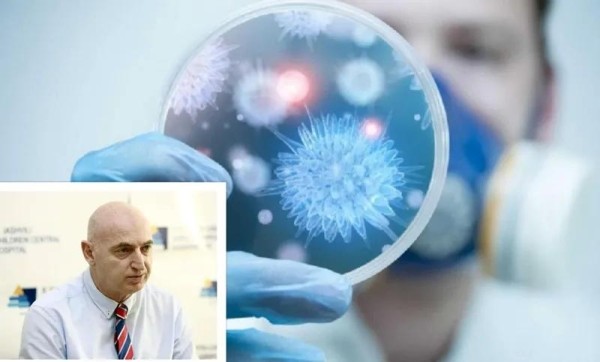
В стране циркулирует вирус гриппа, который заразен – какие симптомы характерны и каковы рекомендации врачей? В стране циркулирует вирус гриппа, который заразен – какие симптомы характерны и каковы рекомендации врачей?

В стране циркулирует вирус гриппа, который заразен – какие симптомы характерны и каковы рекомендации врачей?
По информации медицинского директора Центральной детской больницы им. Иашвили, профессора ТГМУ Иване Чхаидзе, «статистика вируса гриппа в стране на восходящей кривой».
Как отметил Чхаидзе, на 49-й календарной неделе 2023 года подтвержденные случаи гриппа составили 16%, а через 2 недели этот показатель стал 27%.
По его словам, за последние 2 недели число лабораторно подтвержденных случаев гриппа увеличилось вдвое.
«Грипп стал в стране доминантным вирусом. Статистика по вирусу гриппа имеет восходящую кривую. Если посмотреть на данные Национального центра контроля заболеваний, сравнить данные 49-й и 51-й недель 2023 года, количество лабораторно подтвержденных случаев гриппа практически удвоилось. Если на 49-й неделе показатель составлял 16%, то через 2 недели этот показатель стал 27%. Температура 38 градусов и выше, сильная головная боль, боль в суставах и мышцах, общая слабость указывает на существование вируса гриппа. У детей ко всему этому добавляется сонливость, отказ от еды, капризность. Все это указывает на существование вируса гриппа, особенно у маленьких детей, в этом случае управление должно вестись врачом», — сказал Чхаидзе в медиа-центре «Мтавари».
По его словам, грипп заразен и инфицированный ребенок или взрослый опасен для окружающих.
«Рекомендация касается симптоматического лечения. При температуре (38 и выше) применение жаропонижающих средств, прием большого количества жидкости — это может быть чай, вода, свежеприготовленный сок. Обязательно оставайтесь дома.
Грипп заразен и будь то ребенок или взрослый, опасен для других, поэтому, если у вас есть эти симптомы, очень важно оставаться дома», — отмечает Иване Чхаидзе.